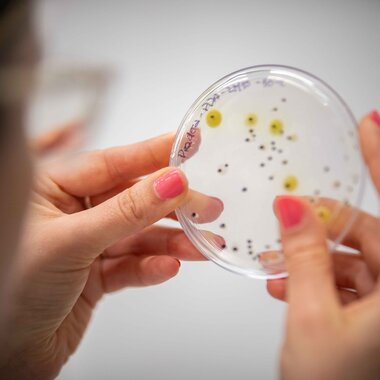
Ecología y Geología- Práctica Ingeniería Ambiental

estudiá ingeniería
¿Por qué Ingeniería en la UCU?
Retos
Retos durante toda la carrera, que te plantearán desafíos reales con empresas del medio y promoverán el aprendizaje práctico y colaborativo.
Doble titulación
Posibilidad de doble titulación nacional en 5+1 años de Ingeniería Industrial con el Institut Catholique d'Arts et Métiers (ICAM) en Francia.
Laboratorios
Laboratorios diseñados especialmente para el aprendizaje de estas disciplinas, con equipamiento de vanguardia en electrónica, robótica, prototipado, microchips y más.
Profesores
Profesores referentes en el ámbito profesional y académico con los que tendrás un vínculo cercano y feedback continuo
Horarios compatibles
Compatibilizá tus estudios con otras responsabilidades laborales o personales.
Aprendizaje
Grupos reducidos que permiten una formación dinámica y personalizada